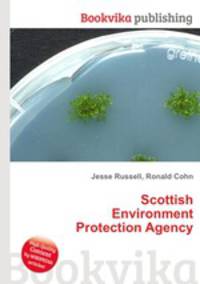
Scottish Environment Protection Agency

Поиск книг, учебников, пособий в онлайн-магазинах
Scottish Environment Protection Agency
Автор: Jesse Russell,Ronald Cohn, 102 стр., издатель: "Книга по Требованию", ISBN: 978-5-5087-7744-9High Quality Content by WIKIPEDIA articles! The Scottish Environment Protection Agency (SEPA) (Scottish Gaelic Buidheann Dion Arainneachd na h-Alba) is Scotland’s environmental regulator. Its main role is to protect and improve Scotland's environment. SEPA does this by helping business and industry to understand their environmental responsibilities, enabling customers to comply with legislation and good practice and to realise the many economic benefits of good environmental practice. One of the ways SEPA does this is through the NetRegs environmental guidance service. It protects communities by regulating activities that can cause harmful pollution and by monitoring the quality of Scotland's air, land and water. The regulations it implements also cover the storage, transport and disposal of radioactive materials. Данное издание представляет собой компиляцию сведений, находящихся в свободном доступе в среде Интернет в целом, и в информационном сетевом ресурсе "Википедия" в частности....
Рейтинг книги: 



 5 из 5, 8 голос(-ов).
5 из 5, 8 голос(-ов).




 5 из 5, 8 голос(-ов).
5 из 5, 8 голос(-ов).




